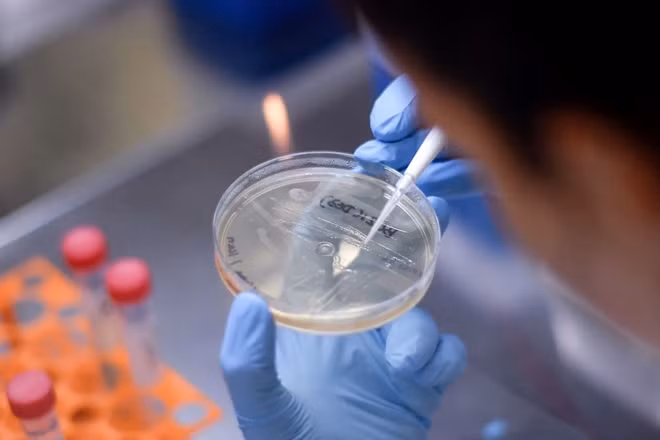

|
|









(GLO)- Cục Phát thanh, Truyền hình và Thông tin điện tử phối hợp với Công ty Truyền thông Netspace vừa chính thức giới thiệu Cổng thông tin và Cơ sở dữ liệu KOL Việt Nam tại địa chỉ kol.gov.vn.

Siêu máy tính LineShine của Trung Quốc vừa vượt qua các đối thủ Mỹ để trở thành hệ thống mạnh nhất thế giới.

(GLO)- Amazon Web Services (AWS) vừa chính thức vận hành AWS Local Zone tại Hà Nội, đánh dấu lần đầu tiên hạ tầng điện toán đám mây do tập đoàn này trực tiếp quản lý hiện diện tại Việt Nam.

(GLO)- Giới chức Brazil đang khẩn trương điều tra vụ tấn công mạng nghiêm trọng nhằm vào hệ thống cảnh báo quốc gia sau khi hàng loạt thông báo khẩn cấp giả mạo được phát tán tới điện thoại của người dân trên khắp cả nước, gây hoang mang trong dư luận.

(GLO)- Gần 17 năm gắn bó với Trường Cao đẳng Kỹ thuật Công nghệ Quy Nhơn, thầy Lê Tấn Hòa (SN 1985, giảng viên Khoa Điện tử - Tin học) không ngừng nghiên cứu, sáng tạo các mô hình, thiết bị đào tạo từ chính nhu cầu thực tiễn của giảng đường.

(GLO)- Thói quen tiếp nhận thông tin của người dân Hàn Quốc đang có sự dịch chuyển mạnh mẽ từ các cổng thông tin và báo điện tử truyền thống sang nền tảng video trực tuyến, đặc biệt là YouTube.

Theo Quy định về AI (AI Act) sẽ có hiệu lực vào ngày 2/8, nhà cung cấp chatbot và hệ thống AI tương tác trực tiếp với người dùng phải thông báo rõ ràng về bản chất phi con người của tương tác đó.

(GLO)- Sáng 22-6, tại Trung tâm Quốc tế Khoa học và Giáo dục liên ngành (phường Quy Nhơn Nam) đã diễn ra Hội thảo Khoa học quốc tế “Kết nối vùng cao: Miền Trung trong quá trình kiến tạo Việt Nam toàn cầu”.

(GLO)- Từ ngày 1-7-2026, Thông tư số 48/2026/TT-BCA của Bộ Công an chính thức có hiệu lực, lần đầu tiên đưa vào áp dụng Quy chuẩn kỹ thuật quốc gia QCVN 11:2026/BCA về yêu cầu an ninh mạng cơ bản đối với thiết bị camera giám sát sử dụng giao thức Internet (camera IP).




Nhiều người thường bỏ qua biểu tượng chiếc lá trên Google Maps mà không biết đây là tính năng hữu ích.

Bộ “10 quy tắc sử dụng AI trong hoạt động báo chí” được ban hành nhằm định hướng chuẩn mực nghề nghiệp cho việc ứng dụng trí tuệ nhân tạo trong các cơ quan báo chí Việt Nam.

(GLO)- Chiều 18-6, tại Trung tâm Quốc tế Khoa học và Giáo dục liên ngành (ICISE), ông Brad Marston - Chủ tịch Hội Vật lý Hoa Kỳ (APS), Giáo sư Vật lý tại Đại học Brown (Hoa Kỳ) đã có buổi nói chuyện đại chúng với chủ đề “Các loại sóng có nguồn gốc tô-pô trong hệ chất lưu của Trái Đất và xa hơn nữa”.

(GLO)- Dù dịch vụ Internet vệ tinh Starlink tại Việt Nam chưa chính thức được thương mại hóa rộng rãi, thị trường mua bán thiết bị Starlink “xách tay” đang diễn ra khá sôi động trên các nền tảng mạng xã hội.

(GLO)- Google vừa phát hành bản cập nhật bảo mật khẩn cấp cho trình duyệt Chrome, khắc phục tới 74 lỗ hổng bảo mật, trong đó có nhiều lỗi được đánh giá ở mức nghiêm trọng, tiềm ẩn nguy cơ cho phép tin tặc thực thi mã độc từ xa và chiếm quyền kiểm soát thiết bị của người dùng.

(GLO)- Sự phát triển mạnh mẽ của internet, mạng xã hội và trí tuệ nhân tạo (AI) đang tạo ra những thay đổi sâu sắc trong đời sống xã hội.

(GLO)- Lần đầu tiên tại Việt Nam, Cổng thông tin và Cơ sở dữ liệu về KOL chính thức được đưa vào vận hành tại địa chỉ kol.gov.vn.

(GLO)- Các chuyên gia công nghệ hàng đầu thế giới vừa đưa ra cảnh báo về tốc độ phát triển của trí tuệ nhân tạo (AI), công nghệ này đang tiến gần đến ngưỡng mà con người không còn thực sự hiểu rõ cách nó vận hành, trong khi AI ngày càng hiểu sâu hơn về hành vi, tâm lý và động cơ của con người.

(GLO)- Chính phủ Anh vừa công bố gói biện pháp bảo vệ trẻ em trên môi trường số, trong đó nổi bật là quy định cấm trẻ em dưới 16 tuổi sử dụng mạng xã hội.




(GLO)- Sự phát triển của trí tuệ nhân tạo (AI) đang đặt ra nhiều câu hỏi về quyền sở hữu trí tuệ đối với các sản phẩm do công nghệ này tạo ra. Từ tranh vẽ, âm nhạc đến các sáng chế, việc xác định ai là chủ sở hữu hợp pháp vẫn là vấn đề gây tranh luận tại nhiều quốc gia, trong đó có Việt Nam.

(GLO)- Ngày 15-6, hàng loạt điểm giao dịch của các nhà mạng trên cả nước ghi nhận lượng người dân đến xác thực thông tin thuê bao tăng đột biến sau khi quy định khóa SIM một chiều đối với các thuê bao chưa hoàn tất xác thực chính thức được áp dụng.

(GLO)- Theo bảng xếp hạng của Nature Index, Trung tâm Quốc tế Khoa học và Giáo dục liên ngành (ICISE) hiện đứng thứ 6 tại Việt Nam trong lĩnh vực Khoa học Vật lý, giai đoạn từ ngày 1-2-2025 đến 31-1-2026.

(GLO)- Từ ngày 1-7, thông tin lý lịch tư pháp của công dân Việt Nam và người nước ngoài từ đủ 16 tuổi trở lên sẽ được tích hợp và hiển thị trên ứng dụng VNeID kể từ thời điểm được cấp phiếu lý lịch tư pháp điện tử lần đầu.

(GLO)- Công ty AI Anthropic vừa buộc phải gỡ bỏ hai mô hình trí tuệ nhân tạo tiên tiến nhất của mình là Claude Fable 5 và Mythos 5 chỉ ba ngày sau khi công bố, theo yêu cầu từ chính phủ Mỹ.

(GLO)- Một tòa án tại Đức vừa đưa ra phán quyết mang tính bước ngoặt khi yêu cầu Google phải chịu trách nhiệm đối với các thông tin sai lệch xuất hiện trong phần tóm tắt do trí tuệ nhân tạo (AI) tạo ra trên công cụ tìm kiếm.